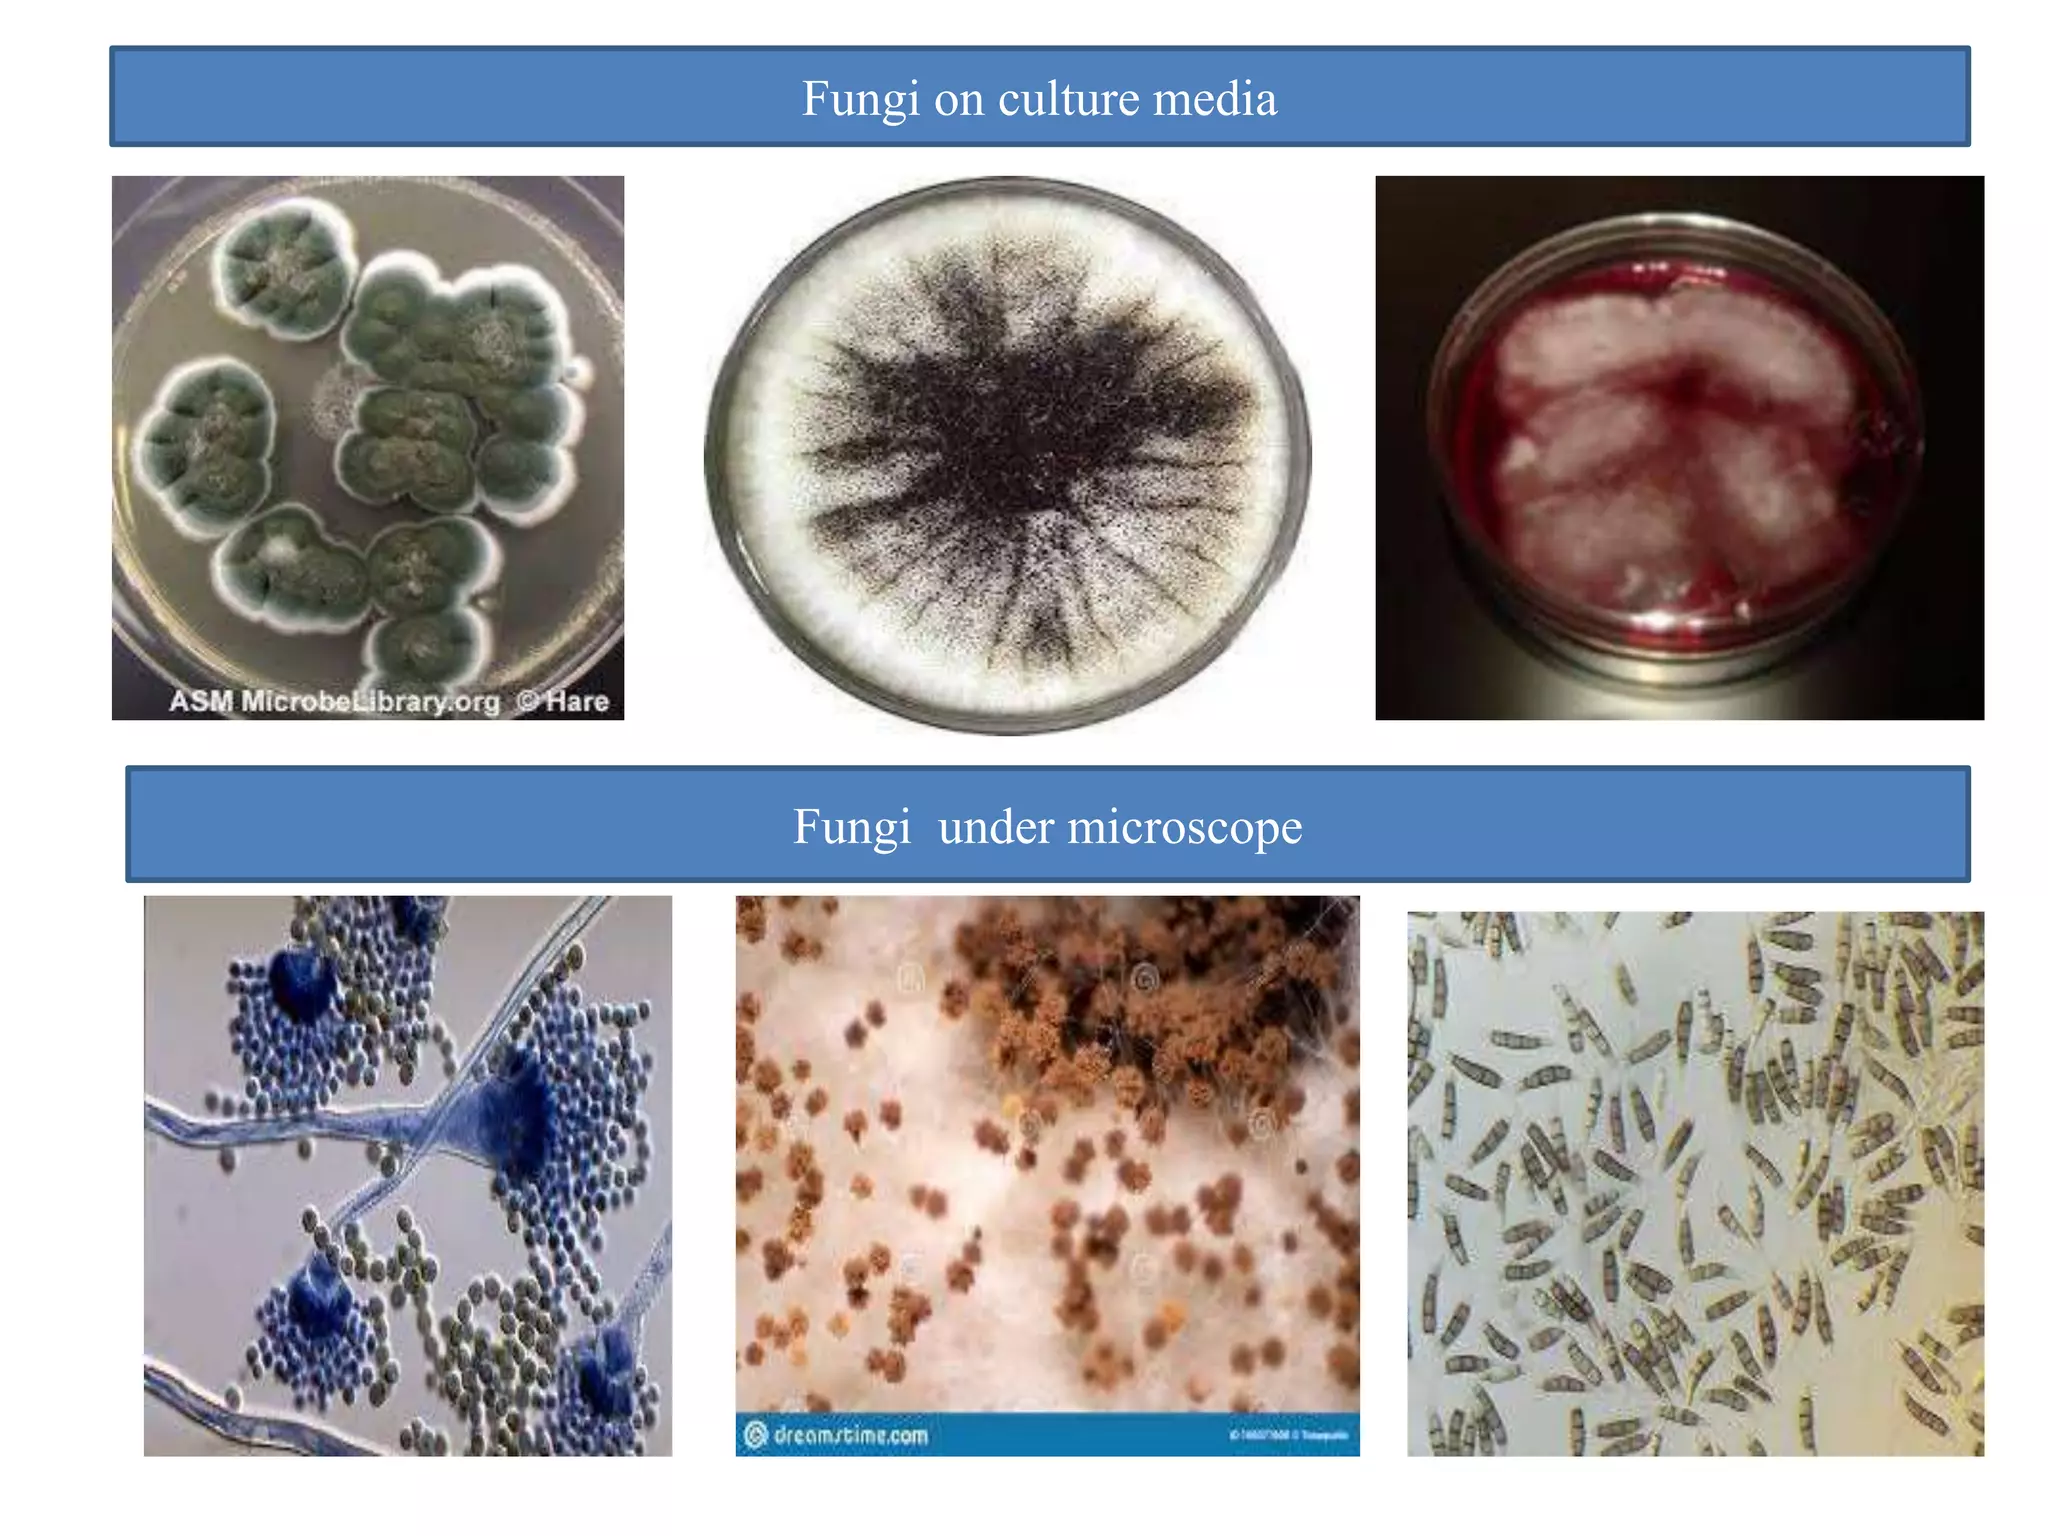
Fungi on culture media
Fungi under microscope

Fungi are eukaryotic organisms that include mushrooms, molds, and yeasts. They obtain nutrients by absorbing dissolved molecules through enzymes secreted into their environment. Fungi play important roles in decomposition, industrial processes like brewing, and producing medications. They can also cause diseases in plants, animals, and humans. Fungi reproduce both sexually through spores and asexually through fragmentation.